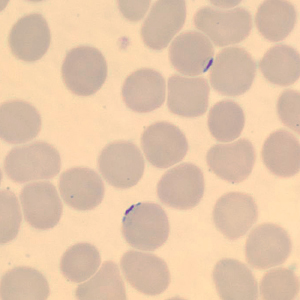
Case323_E.jpg

Case #323 – May, 2012
A 50-year-old man from Cambodia was admitted to the hospital for recurrent fevers. Blood specimens were collected in EDTA and sent to Hematology for routine work-up. Figures A–E show what was observed on a thin smear stained with Wright-Giemsa. The case was originally reported as Plasmodium falciparum and the patient was treated accordingly. One month later, the patient returned to the hospital, again with recurrent fevers. There was no documented international travel between hospital visits. A second blood specimen was collected in EDTA and sent to Hematology for work-up. Images F–I show what was observed on a thin smear stained with Wright-Giemsa. After the second examination, digital images from both collection dates were sent to DPDx for diagnostic assistance. What is your diagnosis? Based on what criteria? What further testing, if any, would you recommend?

Figure A

Figure B

Figure C

Figure D
Figure E

Figure F

Figure G

Figure H

Figure I
This case and images were kindly provided by the California Department of Health, Richmond, CA.
Images presented in the DPDx case studies are from specimens submitted for diagnosis or archiving. On rare occasions, clinical histories given may be partly fictitious.
DPDx is an educational resource designed for health professionals and laboratory scientists. For an overview including prevention, control, and treatment visit www.cdc.gov/parasites/.